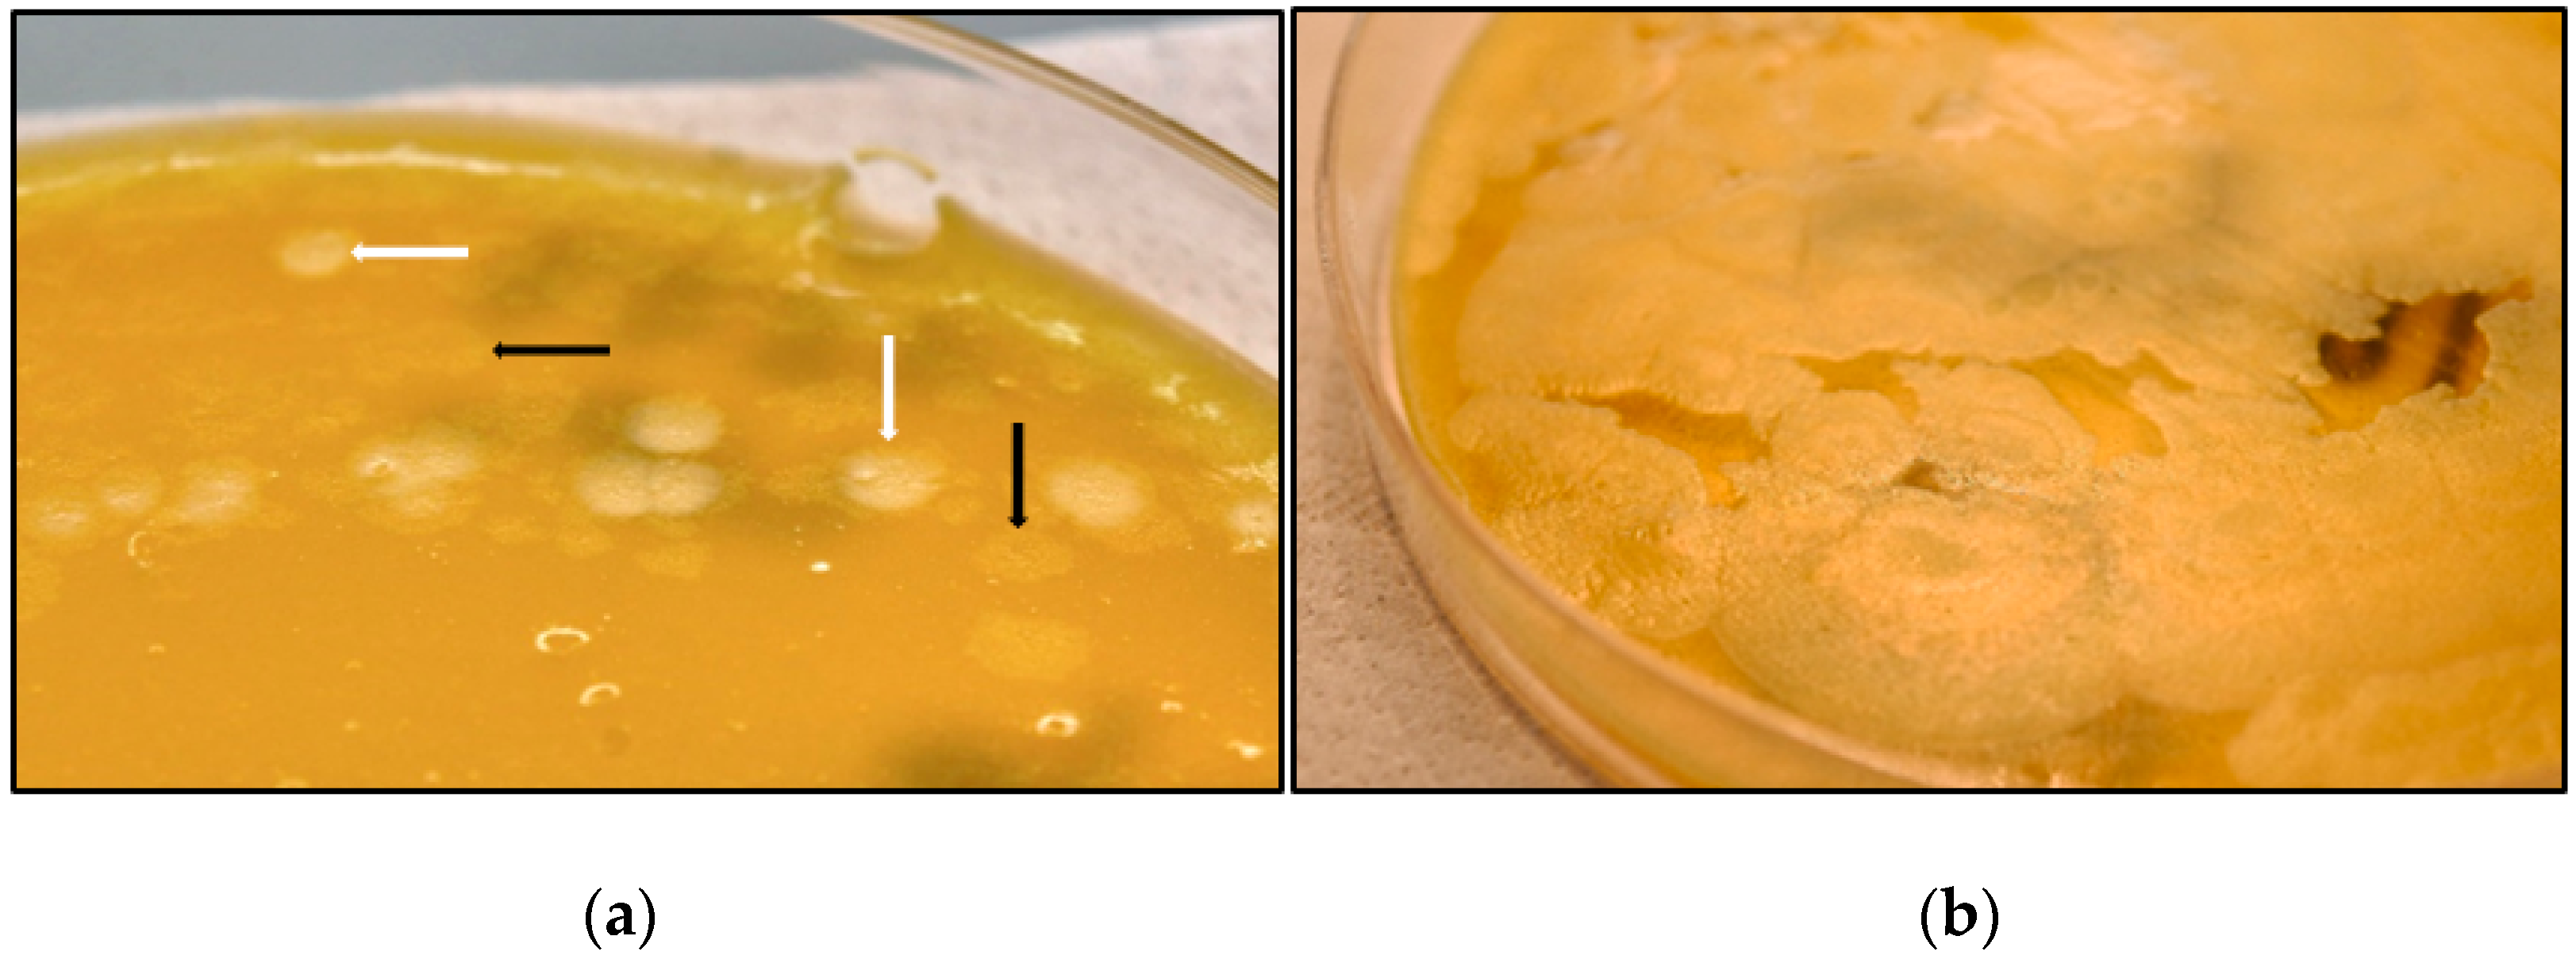
Toxins 10 00248 g001 Toxins 10 00248 g001

Detection of Clostridium tetani Neurotoxins Inhibited In Vivo by Botulinum Antitoxin B: Potential for Misleading Mouse Test Results in Food Controls
Abstract
1. Introduction
2. Results
3. Discussion
4. Materials and Methods
4.1. Detection of Botulinum Neurotoxin-Producing Clostridia by the Mouse Bioassay
4.2. PCR Protocols for Detecting and Characterizing BoNT-Encoding Genes
4.3. Bacteriological Examination
4.4. ELISA Assay
4.5. Experiments on Animals
Author Contributions
Funding
Acknowledgments
Conflicts of Interest
References
- Peck, M.W.; Smith, T.J.; Anniballi, F.; Austin, J.W.; Bano, L.; Bradshaw, M.; Cuervo, P.; Cheng, L.W.; Derman, Y.; Dorner, B.G.; et al. Historical Perspectives and Guidelines for Botulinum Neurotoxin Subtype Nomenclature. Toxins 2017, 9, 38. [Google Scholar] [CrossRef] [PubMed]
- Rossetto, O.; Pirazzini, M.; Montecucco, C. Botulinum Neurotoxins: Genetic, Structural and Mechanistic Insights. Nat. Rev. Microbiol. 2014, 12, 535–549. [Google Scholar] [CrossRef] [PubMed]
- Barash, J.R.; Arnon, S.S. A Novel Strain of Clostridium Botulinum that Produces Type B and Type H Botulinum Toxins. J. Infect. Dis. 2013, 209, 183–191. [Google Scholar] [CrossRef] [PubMed]
- Zhang, S.; Masuyer, G.; Zhang, J.; Shen, Y.; Lundin, D.; Henriksson, L.; Miyashita, S.; Martínez-Carranza, M.; Dong, M.; Stenmark, P. Identification and Characterization of a Novel Botulinum Neurotoxin. Nat. Commun. 2017, 8, 14130. [Google Scholar] [CrossRef] [PubMed]
- Johnson, E.A.; Montecucco, C. Botulism. In Handbook of Clinical Neurology; Goudin, D.S., Ed.; Elsevier: New York, NY, USA, 2008; pp. 333–368. [Google Scholar]
- Peck, M.W. Biology and Genomic Analysis of Clostridium Botulinum. Adv. Microb. Physiol. 2009, 55, 183–320. [Google Scholar] [PubMed]
- Lindstrom, M.; Korkeala, H. Laboratory Diagnostics of Botulism. Clin. Microbiol. Rev. 2006, 19, 298–314. [Google Scholar] [CrossRef] [PubMed]
- AOAC International. AOAC International. AOAC Official Method 977.26 (sec 17.7.01) Clostridium botulinum and its toxins in food. In Official Methods of Analysis, 17th ed.; AOAC International: Gaithersburg, MD, USA, 2001. [Google Scholar]
- Montecucco, C.; Schiavo, G. Structure and Function of Tetanus and Botulinum Neurotoxins. Q. Rev. Biophys. 1995, 28, 423–472. [Google Scholar] [CrossRef] [PubMed]
- Eisel, U.; Jarausch, W.; Goretzki, K.; Henschen, A.; Engels, J.; Weller, U.; Hudel, M.; Habermann, E.; Niemann, H. Tetanus Toxin: Primary Structure, Expression in E. Coli, and Homology with Botulinum Toxins. EMBO J. 1986, 5, 2495–2502. [Google Scholar] [PubMed]
- Masuyer, G.; Conrad, J.; Stenmark, P. The Structure of the Tetanus Toxin Reveals pH-Mediated Domain Dynamics. EMBO Rep. 2017, 18, 1306–1317. [Google Scholar] [CrossRef] [PubMed]
- Centers for Disease Control and Prevention. Botulism in the United States, 1899–1996. Handbook for Epidemiolosts, Clinicians and Laboratory Workers. 1998. Available online: http://www.cdc.gov/ncidod/dbmd/diseaseinfo/files/botulism.pdf (accessed on 2 February 2018).
- Matsuda, M.; Sugimoto, N.; Ozutsumi, K.; Hirai, T. Acute Botulinum-Like Intoxication by Tetanus Neurotoxin in Mice. Biochem. Biophys. Res. Commun. 1982, 104, 799–805. [Google Scholar] [CrossRef]
- Konig, K.; Ringe, H.; Dorner, B.G.; Diers, A.; Uhlenberg, B.; Muller, D.; Varnholt, V.; Gaedicke, G. Atypical Tetanus in a Completely Immunized 14-Year-Old Boy. Pediatrics 2007, 120, e1355-8. [Google Scholar] [CrossRef] [PubMed]
- Sesardic, T.; (National Institute for Biological Standards and Control, Hertfordshire, UK). Personal communication, 2017.
- Tsuzuki, K.; Yokosawa, N.; Syuto, B.; Ohishi, I.; Fujii, N.; Kimura, K.; Oguma, K. Establishment of a Monoclonal Antibody Recognizing an Antigenic Site Common to Clostridium Botulinum Type B, C1, D, and E Toxins and Tetanus Toxin. Infect. Immun. 1988, 56, 898–902. [Google Scholar] [PubMed]
- Jousimies-Somer, R.H.; Summanen, P.; Citron, D.M.; Baron, E.J.; Waxler, H.M.; Finegold, S.M. Advanced identification methods. In Wadsworth-KTL Anaerobic Bacteriology Manual, 6th ed.; Hoffman, S., Ed.; Star Publ.: Seoul, Korea, 2002; pp. 81–132. ISBN 978-0898632095. [Google Scholar]
- Hatheway, C.L. Toxigenic Clostridia. Clin. Microbiol. Rev. 1990, 3, 66–98. [Google Scholar] [CrossRef] [PubMed]
- Lilly, T., Jr.; Harmon, S.; Kautter, D.; Solomon, H.; Lynt, R., Jr. An Improved Medium for Detection of Clostridium Botulinum Type E. J. Milk Food Technol. 1971, 34, 492–497. [Google Scholar] [CrossRef]
- De Medici, D.; Anniballi, F.; Wyatt, G.M.; Lindström, M.; Messelhäußer, U.; Aldus, C.F.; Delibato, E.; Korkeala, H.; Peck, M.W.; Fenicia, L. Multiplex PCR for Detection of Botulinum Neurotoxin-Producing Clostridia in Clinical, Food, and Environmental Samples. Appl. Environ. Microbiol. 2009, 75, 6457–6461. [Google Scholar] [CrossRef] [PubMed]
- Woudstra, C.; Skarin, H.; Anniballi, F.; Fenicia, L.; Bano, L.; Drigo, I.; Koene, M.; Bäyon-Auboyer, M.; Buffereau, J.; De Medici, D. Neurotoxin Gene Profiling of Clostridium Botulinum Types C and D Native to Different Countries within Europe. Appl. Environ. Microbiol. 2012, 78, 3120–3127. [Google Scholar] [CrossRef] [PubMed]
- Bano, L.; Drigo, I.; Tonon, E.; Berto, G.; Tavella, A.; Woudstra, C.; Capello, K.; Agnoletti, F. Evidence for a Natural Humoral Response in Dairy Cattle Affected by Persistent Botulism Sustained by Non-Chimeric Type C Strains. Anaerobe 2015, 36, 25–29. [Google Scholar] [CrossRef] [PubMed]
- Bano, L.; Drigo, I.; Tonon, E.; Pascoletti, S.; Puiatti, C.; Anniballi, F.; Auricchio, B.; Lista, F.; Montecucco, C.; Agnoletti, F. Identification and Characterization of Clostridium Botulinum Group III Field Strains by Matrix-Assisted Laser Desorption-Ionization Time-of-Flight Mass Spectrometry (MALDI-TOF MS). Anaerobe 2017, 48, 126–134. [Google Scholar] [CrossRef] [PubMed]
- Shone, C.; Tranter, H. Growth of clostridia and preparation of their neurotoxins. In Clostridial Neurotoxins; Springer: Berlin, Germany, 1995; pp. 143–160. [Google Scholar]

| Antitoxin | Producer | Antitoxin Titre | Number of Dead Mice at 24, 48 and 72 h Post Inoculation | ||
|---|---|---|---|---|---|
| 24 h | 48 h | 72 h | |||
| Botulinum trivalent antitoxin A, B, E | CDC | >10 UI/mL | 0 | 0 | 0 |
| Botulinum antitoxin A | CDC | >10 UI/mL | 2 | - | - |
| Botulinum antitoxin B | CDC | >10 UI/mL | 0 | 0 | 0 |
| Botulinum antitoxin C | CDC | >10 UI/mL | 2 | - | - |
| Botulinum antitoxin D | CDC | >10 UI/mL | 2 | - | - |
| Botulinum antitoxin E | CDC | ≥10 UI/mL | 2 | - | - |
| Botulinum antitoxin F | CDC | ≥10 UI/mL | 2 | - | - |
| Botulinum antitoxin B | NIBSC | 10 UI/mL | 1 | 1 | - |
| Botulinum antitoxin B | NIBSC | 100 UI/mL | 0 | 0 | 0 |
| Botulinum antitoxin B | NIBSC | 1000 UI/mL | 0 | 0 | 0 |
| Tetanus antitoxin | NIBSC | 10 UI/mL | 0 | 0 | 0 |
| Further samples tested | |||||
| Untreated supernatant | - | - | 2 | - | - |
| Heat treated supernatant | - | - | 0 | 0 | 0 |
© 2018 by the authors. Licensee MDPI, Basel, Switzerland. This article is an open access article distributed under the terms and conditions of the Creative Commons Attribution (CC BY) license (http://creativecommons.org/licenses/by/4.0/).
Share and Cite
Bano, L.; Tonon, E.; Drigo, I.; Pirazzini, M.; Guolo, A.; Farina, G.; Agnoletti, F.; Montecucco, C. Detection of Clostridium tetani Neurotoxins Inhibited In Vivo by Botulinum Antitoxin B: Potential for Misleading Mouse Test Results in Food Controls. Toxins 2018, 10, 248. https://doi.org/10.3390/toxins10060248
Bano L, Tonon E, Drigo I, Pirazzini M, Guolo A, Farina G, Agnoletti F, Montecucco C. Detection of Clostridium tetani Neurotoxins Inhibited In Vivo by Botulinum Antitoxin B: Potential for Misleading Mouse Test Results in Food Controls. Toxins. 2018; 10(6):248. https://doi.org/10.3390/toxins10060248
Chicago/Turabian StyleBano, Luca, Elena Tonon, Ilenia Drigo, Marco Pirazzini, Angela Guolo, Giovanni Farina, Fabrizio Agnoletti, and Cesare Montecucco. 2018. "Detection of Clostridium tetani Neurotoxins Inhibited In Vivo by Botulinum Antitoxin B: Potential for Misleading Mouse Test Results in Food Controls" Toxins 10, no. 6: 248. https://doi.org/10.3390/toxins10060248
APA StyleBano, L., Tonon, E., Drigo, I., Pirazzini, M., Guolo, A., Farina, G., Agnoletti, F., & Montecucco, C. (2018). Detection of Clostridium tetani Neurotoxins Inhibited In Vivo by Botulinum Antitoxin B: Potential for Misleading Mouse Test Results in Food Controls. Toxins, 10(6), 248. https://doi.org/10.3390/toxins10060248

